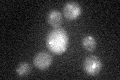
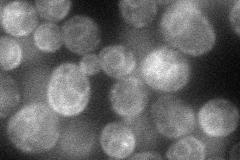
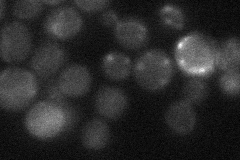

View description
Constitutively expressed acid phosphatase similar to Pho5p; brought to the cell surface by transport vesicles; hydrolyzes thiamin phosphates in the periplasmic space, increasing cellular thiamin uptake; expression is repressed by thiamin
Localization:
Intensity:
Fold change:
Significance:
-
C’ GFP library in SD
vacuole26.63 -
N' NOP1pr-GFP in SD
ER49.3639 -
N' TEF2pr-mCherry in SD

cell periphery,vacuole21.5575 -
N' NATIVEpr-GFP in SD
below threshold16.6832 -
N' TEF2pr-VC and Cyto-VN in SD

#N/A0 -
C’ GFP library in SD+DTT

vacuole17.810.66Yes -
C’ GFP library in SD+H2O2

vacuole18.740.7Yes -
C’ GFP library in Starvation Media

vacuole15.40.57Yes -
C’ GFP library on the background of Pup2-DaMP

N/A -
C’ GFP library on the background of CCT mutant

N/A0N/AYes
